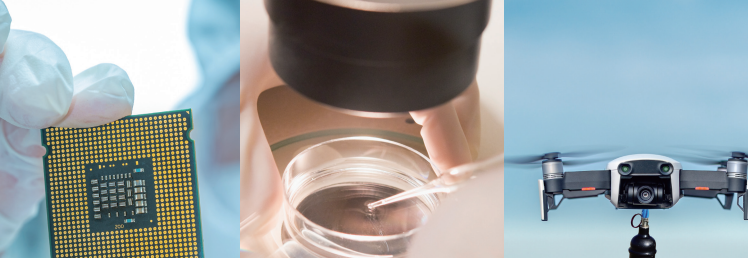

티스토리 뷰
목차
한양대 에리카 캠퍼스는 공학, 디자인, 경영 등 다양한 분야에서 두각을 나타내며 주목받는 대학입니다. 특히, 수시 전형에서 매년 높은 경쟁률과 높은 등급 컷으로 학생들의 뜨거운 관심을 받고 있죠. 오늘은 2025학년도 한양대 에리카 수시 등급 컷, 경쟁률, 예비번호 및 논술 기출문제 등을 한눈에 살펴보려 합니다!
한양대 에리카를 학생들이 선택하는 이유


1. 실용적인 전공 중심의 커리큘럼 – 산업과 연결되는 실무 중심 교육으로 취업 경쟁력을 높여주는 프로그램이 가득합니다.
2. 산업-대학 협력의 강점 – 다양한 기업 및 연구기관과 협력해 현장 경험을 쌓을 수 있는 기회를 제공합니다.
3. 적극적인 진로 지원 – 학생 맞춤형 상담과 프로그램을 통해 진로를 명확히 세울 수 있도록 든든하게 뒷받침합니다.
4. 탁월한 캠퍼스 환경 – 쾌적하고 세련된 캠퍼스 시설과 함께 학생들의 창의적 학습을 지원합니다.
| 한양대학교 ERICA 캠퍼스의 위치 경기도 안산시 상록구 한양대학로 55에 위치해 있습니다. 대중교통을 이용하면 서울 지하철 4호선과 수인분당선이 교차하는 '한대앞역'에서 하차하신 후, 한양대학교 셔틀버스를 이용하시면 캠퍼스까지 약 10분 정도 소요됩니다. 자가용을 이용하실 경우, 서해안 고속도로 매송 IC에서 약 7km 거리에 위치해 있으며, 서울 강남이나 판교에서 출발하신다면 과천-의왕-봉담간 고속화도로를 통해 약 12km 거리에 위치해 있습니다. |
한양대 ERICA 모집학과명과 모집전형명


2026학년도 한양대 에리카의 모집단위(모집전공)와 모집전형명은 아래와 같습니다.
| 2026학년도 한양대 에리카 모집단위 |
| 건축학부(건축학전공) 건축학전공(5년) 건축학부(건축공학전공) 건축공학전공(4년) 건설환경공학과 교통·물류공학과 전자공학부 배터리소재화학공학과 기계공학과 산업경영공학과 로봇공학과 에너지바이오학과 해양융합공학과 융합시스템공학과 스마트융합공학부 소재·부품융합전공, 로봇융합전공, 스마트ICT융합전공, 건축IT융합전공, 스마트건축구조시공융합전공 컴퓨터학부 컴퓨터전공, 지능형클라우드전공 컴퓨터학부(컴퓨터전공) 컴퓨터학부(지능형클라우드전공) ICT융합학부 데이터인텔리전스전공, 디자인컨버전스전공 인공지능학과 수리데이터사이언스학과 약학과 차세대반도체융합공학부 신소재·반도체공학전공, 반도체·디스플레이공학전공 차세대반도체융합공학부(신소재·반도체공학전공) 차세대반도체융합공학부(반도체·디스플레이공학전공) 바이오신약융합학부 분자의약전공, 바이오나노공학전공 바이오신약융합학부(분자의약전공) 바이오신약융합학부(바이오나노공학전공) 국방지능정보융합공학부(지능정보양자공학전공) 국방지능정보융합공학부(국방전략기술공학과) 글로벌문화통상학부 광고홍보학과 미디어학과 문화인류학과 문화콘텐츠학과 경제학부 경영학부 보험계리학과 회계세무학과 LIONS자율전공학부 디자인계열 스포츠과학부 무용예술학과 실용음악학과 |
| 2026학년도 한양대 에리카 모집전형 |
| 학생부교과(지역균형선발) 학생부종합(서류형) 학생부종합(면접형) 학생부종합(고른기회) 학생부종합(국방전략기술공학) 학생부종합(특성화고졸재직자) 학생부종합(조기취업형 계약학과) 학생부종합(서해 5도) 재능우수자(디자인) 재능우수자(체육인재) 재능우수자(체육특기) 재능우수자(무용) 재능우수자(실용음악) |
한양대 에리카 수시 경쟁률


지난해 2025학년도 한양대 에리카의 수시모집 전체 경쟁률은 총 모집인원 1,464명이며 지원인원은 25,200명으로 17.21 대 1의 경쟁률을 보였습니다. 전형별로 모집인원과 지원인원 그리고 경쟁률은 아래 표와 같으며, 학과별 경쟁률은 아래 빨간 링크를 통해 확인해주시기 바랍니다.
한양대 ERICA 수시 정시 등급 컷 충원 합격 입시결과


지난해 수시 학생부종합 서류, 면접, 첨단융합인재 전형과 학생부교과 지역균형선발 지균의 등급 컷은 아래와 같습니다. 표에 보이지 않는 학과는 아래 빨강색 링크를 통해 확인해주시기 바랍니다. 정시 등급 컷은 세번째 표입니다.



한양대 ERICA 논술 기출문제 출제의도 및 예시 답안

한양대에리카는 2023학년도까지 논술전형을 운영했다. 해당 내용을 보고싶다면 아래 그림을 클릭하면 볼 수 있다.
[자료출처 : 한양대 에리카 입시 홈페이지]
✨ 다른 수도권 대학 입시결과 ✨
서울시립대 수시 등급 컷 경쟁률 예비번호 논술 기출문제(2025)
2025학년도 서울시립대학교 수시 지원을 준비하고 있다면, 반드시 확인해야 할 정보들이 있습니다. 수시 등급 컷, 전형별 경쟁률, 예비번호 합격 가능선, 그리고 논술 기출문제까지 이 모든 요소
ok.nowinfonow.com
경희대 수시등급 컷 내신 성적 경쟁률(2025학년도)
경희대학교 수시 대비 2025학년도 수시등급 컷(내신 성적 입시결과), 경쟁률과 2026학년도 수능최저학력에 대해 살펴보겠습니다. 추가적으로 2025학년도 수시모집 논술우수자전형 논술고사 기출문
ok.nowinfonow.com
가천대 수시 등급 컷 경쟁률 입시결과 및 논술 기출문제(2025)
오늘은 2025학년도 가천대학교의 수시 등급 컷과 경쟁률, 입시결과(예비번호 등) 및 논술 기출문제에 대해 알아보겠습니다. 먼저 가천대학교의 특징과 장점을 알아보고, 가천대는 여러개 캠퍼스
ok.nowinfonow.com
수원대 수시 등급 컷 경쟁률 논술 기출문제 및 답안(2025)
오늘은 수원대학교의 캠퍼스의 특징과 장점, 학생들이 선택하는 이유, 모집 학과 및 전공, 모집 전형 및 2025학년도 수시 등급 컷, 경쟁률, 논술 기출문제와 모범답안에 대해 안내해드리겠습니다.
ok.nowinfonow.com


'일반대학(4년)' 카테고리의 다른 글
| 서울시립대 수시 등급 컷 경쟁률 예비번호 논술 기출문제(2025) (0) | 2025.05.30 |
|---|---|
| 수원대 수시 등급 컷 경쟁률 논술 기출문제 및 답안(2025) (0) | 2025.05.29 |
| 가천대 수시 등급 컷 경쟁률 입시결과 및 논술 기출문제(2025) (0) | 2025.05.29 |
| 명지대 수시 등급 컷 입시결과 및 면접고사 기출문항(2025) (0) | 2025.05.29 |
| 경희대 수시등급 컷 내신 성적 경쟁률(2025학년도) (0) | 2025.05.28 |



